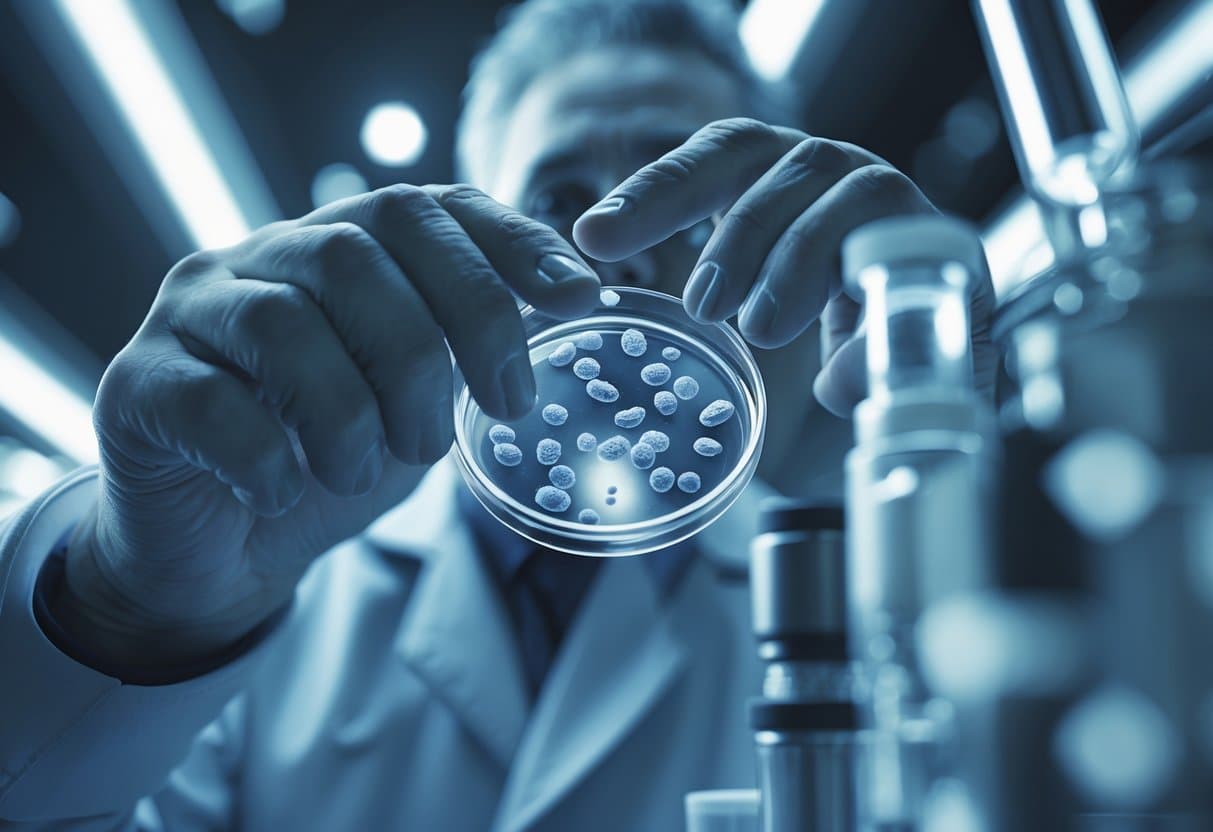
A scientist in a laboratory closely examines a sample vial containing cells, focusing on telomere structures under advanced lighting.
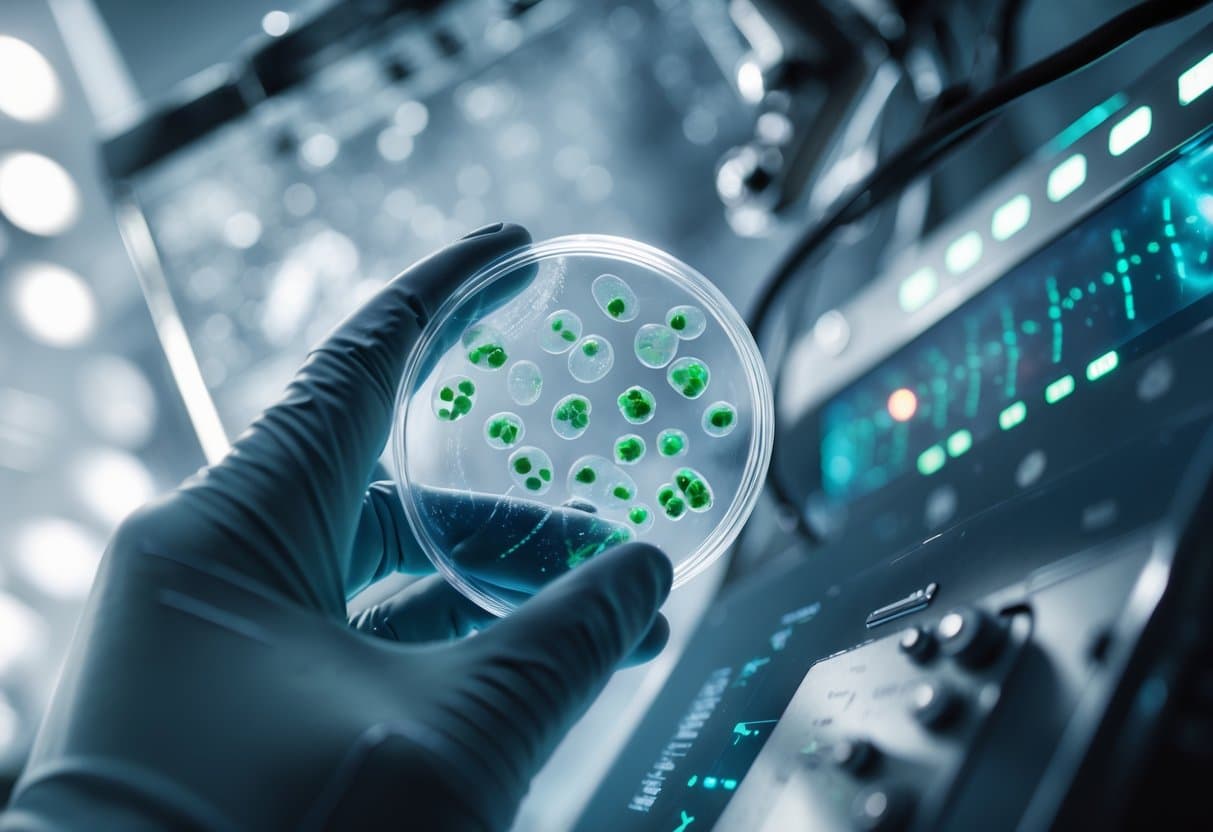
Close-up view of a gloved hand holding a petri dish with cultured cells in a modern laboratory, with a gene sequencing machine and scientific equipment in the background.

Telomere biology disorders affect one in one million Americans and cause devastating complications including bone marrow failure in up to 90% of patients by age 30. These rare genetic conditions result from abnormally short telomeres, the protective caps on chromosomes that maintain cellular health and division capability.
Recent breakthrough clinical trials have demonstrated that gene therapy can successfully elongate telomeres in patients with telomere biology disorders, offering the first targeted treatment for these previously incurable conditions. Elixirgen Therapeutics reported positive results[1] from their EXG-34217 treatment, which achieved sustained telomere lengthening without safety concerns over 24 months.
This emerging therapeutic approach represents a fundamental shift in treatment strategy. Unlike traditional supportive care or bone marrow transplants, gene therapy directly addresses the underlying cellular defect that drives disease progression across multiple organ systems.
Key Takeaways
- Gene therapy treatments can successfully lengthen telomeres in patients with telomere biology disorders without requiring harsh conditioning regimens
- Telomere biology disorders cause bone marrow failure in most patients by age 30 due to critically short chromosome protective caps
- New targeted therapies offer hope for treating the root cause of these rare genetic conditions rather than just managing symptoms
Understanding Telomere Biology Disorders

Telomere biology disorders affect chromosome ends[2] and represent rare genetic conditions with abnormal telomere lengths. These disorders impact approximately one in one million people and can manifest at any age.
Definition and Classification of Telomere Biology Disorders
Telomere biology disorders (TBDs) are rare genetic conditions[3] that arise from mutations in genes responsible for telomere maintenance. These disorders affect the protective DNA-protein structures at chromosome ends.
TBDs include two main categories:
- Disorders with abnormally short telomeres
- Disorders with abnormally long telomeres
Dyskeratosis congenita represents one of the most well-known TBDs[4]. This condition can lead to bone marrow failure by disrupting blood cell production.
The classic presentation involves a mucocutaneous triad of symptoms. However, clinical presentations now extend beyond pediatric bone marrow failure[5] to include adult-onset manifestations.
Clinicians classify these disorders based on genetic mutations and inheritance patterns. Different genes show varying ages of clinical onset and disease severity.
Epidemiology and Prevalence
TBDs affect approximately 340 people in the United States[4], representing one in one million individuals. This makes them extremely rare genetic conditions.
Age Distribution:
- Symptoms can appear in children
- Adult-onset cases occur, sometimes after age 60
- Different genes show typical age groups for clinical manifestations[6]
The disorders affect both males and females equally. Inheritance patterns vary depending on the specific genetic mutation involved.
Geographic distribution appears uniform across populations. However, certain mutations may show higher frequency in specific ethnic groups.
Molecular Pathophysiology
Telomeres are protective structures at chromosome ends that naturally shorten with age. In TBDs, this process becomes disrupted through genetic mutations.
Key Pathophysiological Mechanisms:
- Impaired telomerase enzyme function
- Defective telomere maintenance proteins
- Abnormal telomerase RNA component processing
When telomeres become critically short, cells lose their ability to divide properly. This leads to DNA damage and cellular dysfunction.
Multiple genes harbor pathogenic variants that impair telomere maintenance[7]. Each gene contributes different proportions to the overall TBD spectrum.
The molecular consequences affect stem cell populations most severely. Hematopoietic stem cells show particular vulnerability to telomere dysfunction.
This cellular damage can progress to organ failure and increased cancer risk. The timing and severity depend on the specific genetic defect and telomere length at birth.
Telomere Structure, Function, and Maintenance

Telomeres are DNA-protein structures[3] that protect chromosome ends from degradation during cell division. These protective caps contain specific protein complexes and rely on telomerase for length maintenance in actively dividing cells.
Role and Structure of Telomeres
Telomeres are noncoding repeats of the TTAGGG nucleotide sequence[3] located at chromosome ends. They solve the “end-replication problem” where DNA shortens with each cell division.
The telomere structure includes a T-loop configuration. The single-stranded G-strand terminus inserts into the double-stranded telomeric DNA sequence. This creates a D-loop at the insertion point.
Shelterin protein complex protects telomeres[3] from being recognized as DNA breaks. It contains six key components:
- TRF1 and TRF2: Bind directly to telomeric DNA
- POT1: Binds single-stranded telomeric DNA
- TIN2, TPP1, and RAP1: Form connecting bridges between other proteins
Short telomeres trigger cellular senescence and cell death. Critical telomere shortening results in chromosome end-to-end fusions[3] and genomic instability.
Mechanisms of Telomere Maintenance
Telomerase is a ribonucleoprotein complex that adds telomere repeats[3] to chromosome ends. It contains two essential components: TERT (telomerase reverse transcriptase) and TERC (telomerase RNA component).
TERC provides the template for adding new telomeric DNA sequences. TERT acts as the enzyme that synthesizes the DNA. Together, they maintain telomere length in stem cells and some rapidly dividing cells.
Additional proteins support telomere maintenance:
| Protein | Function |
|---|---|
| Dyskerin | Stabilizes TERC within telomerase complex |
| RTEL1 | Disrupts T-loops for telomere replication |
| CST complex | Synthesizes complementary C-strand DNA |
PARN removes degradation signals from TERC[3], while PAPD5 adds them. This balance controls telomerase RNA stability.
Regulation of Telomere Length
Telomere length varies significantly between cell types and individuals. Average leucocyte telomere length at birth is 10 kb[3], shortening by 27-41 base pairs yearly.
Genetic factors strongly influence telomere length. Inherited variants in telomerase genes affect baseline length and attrition rates. Individuals with African ancestry typically have longer telomeres[3].
Environmental factors also impact telomere maintenance:
- Oxidative stress accelerates shortening
- Chronic inflammation increases attrition rates
- Smoking and obesity reduce telomere length
Different tissues show varying telomere lengths. Testis and stem cell compartments maintain longer telomeres through higher telomerase activity. Blood cells and lung epithelial cells have shorter telomeres due to rapid turnover rates.
Clinical Manifestations and Diagnosis

Telomere biology disorders present with diverse symptoms across multiple organ systems, making early recognition challenging for clinicians. Accurate diagnosis requires understanding the broad disease spectrum and utilizing appropriate genetic testing methods.
Common Presenting Symptoms
Bone marrow failure represents the most serious manifestation of telomere biology disorders. Patients develop low blood cell counts that can be life-threatening.
The classic triad includes abnormal skin pigmentation, nail dystrophy, and oral leukoplakia. These signs appear in about 80% of patients with dyskeratosis congenita.
Pulmonary complications affect many adults with these conditions. Patients may develop lung scarring or breathing problems that worsen over time.
Additional symptoms include:
- Hair loss or premature graying
- Liver disease
- Eye problems like excessive tearing
- Dental abnormalities
- Growth delays in children
Symptoms often appear at different ages. Some patients show signs in childhood while others develop problems as adults.
Disease Spectrum: Dyskeratosis Congenita and Related Disorders
Dyskeratosis congenita is the most recognized telomere biology disorder. It typically includes the classic skin, nail, and mouth symptoms.
Severe forms like Hoyeraal-Hreidarsson syndrome affect infants. These babies have brain problems and very low blood counts.
Milder forms may only cause lung disease in adults. These patients might not have the typical skin changes.
Clinical manifestations vary widely[6] between patients and families. Some people have severe symptoms while relatives have mild problems.
Cancer risk increases significantly in these disorders. Patients develop cancers at younger ages than expected.
The heterogeneous presentation makes diagnosis difficult[3]. Symptoms may appear only after certain triggers like radiation exposure.
Diagnostic Challenges and Criteria
Short telomeres serve as a key diagnostic marker. Telomere length below the 10th percentile suggests a telomere disorder.
Many patients receive delayed diagnoses because symptoms develop slowly. The average time from first symptoms to diagnosis can be several years.
Diagnostic criteria include:
- Clinical features consistent with telomere disorders
- Short telomeres for patient age
- Family history of similar problems
- Genetic variants in telomere-related genes
Some patients have normal telomere lengths despite having genetic variants. This makes diagnosis more complex.
Doctors must consider telomere disorders in patients with unexplained bone marrow failure. Early recognition helps prevent complications from treatments.
Role of Genetic Testing
Next-generation sequencing has improved genetic testing[8] for telomere disorders. At least 16 genes are now linked to these conditions.
Genetic testing confirms diagnosis in about 70% of suspected cases. The remaining patients may have variants in undiscovered genes.
Testing helps predict disease severity and cancer risk. Different gene variants cause different patterns of symptoms.
Comprehensive genetic panels[7] test multiple telomere-related genes at once. This approach is more efficient than testing individual genes.
Benefits of genetic testing:
- Confirms clinical diagnosis
- Guides treatment decisions
- Identifies at-risk family members
- Helps with family planning decisions
Genetic counseling should accompany testing because results affect entire families.
Current Therapeutic Approaches for Telomere Disorders

Treatment options for telomere biology disorders remain limited but include supportive care to manage symptoms, stem cell transplantation for severe cases, and experimental gene therapies showing early promise.
Standard Supportive Care
Supportive care forms the foundation of treatment for patients with telomere biology disorders. This approach focuses on managing complications rather than addressing the underlying telomere dysfunction.
Bone marrow failure requires regular monitoring of blood counts. Patients often need blood transfusions to maintain adequate red blood cell and platelet levels.
Growth factors may help stimulate blood cell production. Erythropoiesis-stimulating agents can reduce transfusion needs in some patients.
Pulmonary complications need careful management. Patients require regular lung function tests and treatment for pulmonary fibrosis when it develops.
Liver problems may occur in certain telomere disorders. Regular monitoring of liver enzymes and function helps detect issues early.
Infection prevention becomes critical due to compromised immune function. Patients should receive appropriate vaccinations and prophylactic antibiotics when needed.
Hematopoietic Stem Cell Transplantation
Hematopoietic stem cell transplantation represents the only curative treatment for bone marrow failure in telomere biology disorders. However, this procedure carries significant risks for these patients.
Traditional conditioning regimens prove too toxic for most patients with telomere disorders. Their cells show extreme sensitivity to radiation and chemotherapy.
Reduced-intensity conditioning protocols have improved outcomes. These gentler approaches lower treatment-related mortality while maintaining transplant success.
HSCs from matched donors can restore normal blood cell production. The new stem cells have normal telomere lengths and function.
Complications remain common even with modified protocols. Patients face increased risks of organ toxicity and poor wound healing.
Long-term outcomes vary significantly. Success depends on patient age, organ function, and donor matching.
Innovative Therapies Under Investigation
Gene therapy approaches target telomere elongation[1] in patients with telomere biology disorders. Early results show promise for addressing the root cause of these conditions.
EXG-34217 represents a breakthrough treatment currently in clinical trials. This therapy uses modified hematopoietic stem cells that express ZSCAN4 protein to lengthen telomeres.
Initial results from two patients showed sustained telomere elongation over 24 months and 5 months respectively. No treatment-related safety concerns emerged during follow-up periods.
The therapy avoids traditional preconditioning regimens. This advantage proves crucial for patients who cannot tolerate standard chemotherapy or radiation.
FDA granted Regenerative Medicine Advanced Therapy designation[9] to EXG-34217 for treating telomere biology disorders with bone marrow failure.
Other experimental approaches include small molecule drugs and alternative RNA therapies. These treatments aim to boost telomerase activity or improve cellular function.
Gene Therapy for Telomere Biology Disorders

Gene therapy approaches for telomere biology disorders focus on lengthening shortened telomeres through direct cellular modification and novel protein expression systems. Recent clinical trials have demonstrated successful telomere elongation using ZSCAN4-based treatments, while emerging RNA therapies offer new delivery mechanisms for these complex genetic conditions.
Mechanisms and Rationale of Gene Therapy
Gene therapy for telomere biology disorders targets the root cause of these conditions by directly addressing telomere shortening at the cellular level. Traditional treatments only manage symptoms, but gene therapy aims to restore normal cellular function.
The primary approach involves modifying hematopoietic stem cells to express proteins that can lengthen telomeres. These modified cells are then reintroduced into the patient’s body where they can produce blood cells with longer, healthier telomeres.
ZSCAN4 protein represents a breakthrough in this field. Unlike telomerase-dependent methods, ZSCAN4 works independently of the telomerase enzyme system. This protein naturally regulates telomere elongation and genome stability in healthy cells.
The mechanism involves extracting CD34+ stem cells from patients, temporarily expressing ZSCAN4 in these cells, then returning them to the patient. This process, called ex vivo modification, allows for precise control over the treatment.
Gene therapy offers particular advantages for telomere biology disorder patients who cannot tolerate traditional bone marrow transplants. These patients often have severe sensitivity to radiation and chemotherapy used in conventional treatments.
Key Clinical Trials and Initial Outcomes
Elixirgen Therapeutics has published encouraging early results[10] from the first clinical trial testing gene therapy for telomere biology disorders. The Phase 1/2 study (NCT04211714) represents a major milestone in treating these rare genetic conditions.
Two patients received EXG-34217, a treatment using ZSCAN4-modified autologous CD34+ hematopoietic stem cells. Both patients showed successful sustained telomere elongation without any treatment-related adverse events over follow-up periods of 24 months and 5 months respectively.
Patient outcomes included:
- Telomere length increased from 3.6 kb to 6.7 kb in lymphocytes for one patient
- Neutrophil counts improved from 1.78×10³/µL to 3.18×10³/µL
- Second patient no longer required G-CSF injections to maintain blood cell counts
- No preconditioning regimen or immunosuppression was needed
The FDA has granted multiple designations[1] to EXG-34217, including Rare Pediatric Disease Designation, Regenerative Medicine Advanced Therapy Designation, and Orphan Drug Designation.
Current enrollment accepts participants aged 12 and older with telomere biology disorders who have developed bone marrow failure. The trial continues to evaluate safety and effectiveness in additional patients.
Emerging RNA and ZSCAN4-Based Therapies
ZSCAN4-based gene therapy represents the most advanced approach currently in clinical testing. This zinc finger protein was originally identified at the National Institute on Aging and plays multiple roles in maintaining cellular health beyond telomere extension.
The protein functions independently of telomerase, making it effective regardless of the specific genetic mutation causing a patient’s telomere biology disorder. This mutation-independent approach offers treatment possibilities for patients with various underlying genetic defects.
Self-replicating RNA therapies are emerging as another promising delivery method. These next-generation RNA approaches[11] offer advantages over traditional mRNA therapies, including longer-lasting protein expression and reduced dosing frequency.
Key advantages of ZSCAN4 therapy:
- Works without telomerase enzyme
- Effective across different genetic mutations
- Restores genome stability
- No chemotherapy or radiation preconditioning required
Research continues into optimizing delivery methods and dosing strategies. Animal studies using AAV9 gene therapy vectors[3] have shown telomere lengthening and improved survival in mouse models of aplastic anemia.
The field is expanding to include combination therapies and improved vector systems that could enhance treatment effectiveness and reduce potential side effects in future clinical applications.
Clinical Considerations and Practical Implications

Gene therapy for telomere disorders requires careful patient selection and ongoing safety monitoring, while regulatory pathways continue to evolve. Current trials like Elixirgen Therapeutics’ EXG-34217 study[1] demonstrate the potential for sustained telomere elongation without major safety concerns.
Patient Selection for Gene Therapy
Clinicians must identify appropriate candidates through comprehensive genetic testing and clinical assessment. Patients with confirmed pathogenic variants in telomere-related genes represent the primary target population.
Key Selection Criteria:
- Documented telomere biology disorder with genetic confirmation
- Evidence of progressive organ dysfunction
- Age 12 years or older (based on current trial protocols)
- Adequate organ function to tolerate treatment
The ongoing Phase 1/2 trial (NCT04211714)[1] focuses on patients with bone marrow failure. These individuals often have dyskeratosis congenita or related conditions.
Clinicians should evaluate disease severity and progression rate. Patients with rapidly declining hematopoietic function may benefit most from early intervention.
Family history and genetic counseling are essential components. Many telomere disorders show inheritance patterns that affect treatment decisions and family planning.
Risks, Benefits, and Monitoring
Gene therapy offers potential benefits but requires careful risk assessment and ongoing surveillance. The treatment approach differs significantly from traditional bone marrow transplantation protocols.
Potential Benefits:
- Sustained telomere elongation in blood cells
- No requirement for preconditioning regimens
- Avoidance of immunosuppressive medications
- Reduced transplant-related complications
Monitoring Requirements:
- Regular telomere length measurements
- Complete blood counts and bone marrow function
- Multi-organ system assessments
- Long-term cancer surveillance
The first patients treated with EXG-34217[1] showed no treatment-related safety concerns over 24 months and 5 months respectively. However, longer follow-up periods are needed.
Clinicians must balance the polarizing therapeutic goals[12] inherent in telomere therapy. While telomere elongation may benefit patients, it could potentially increase cancer risk in some cases.
Regulatory Status and Future Directions
Current gene therapy approaches remain investigational and require regulatory approval through clinical trials. The FDA oversees these treatments under strict protocols.
Elixirgen Therapeutics[1] published initial results in February 2025, marking a significant milestone in telomere disorder treatment. The data represents the first successful sustained telomere elongation in humans.
Current Regulatory Landscape:
- Phase 1/2 trials are ongoing
- No approved therapies exist yet
- Compassionate use may be available in select cases
- International regulatory coordination is developing
Future directions include expanding patient populations and exploring combination therapies. Researchers are investigating telomere-targeted medicine[13] approaches that bridge molecular mechanisms with clinical applications.
Clinicians should stay informed about trial enrollment opportunities and emerging treatment protocols. The field is rapidly evolving with new therapeutic targets being identified.
Frequently Asked Questions
Telomere gene therapy presents unique challenges due to its dual potential for anti-aging benefits and cancer risks. Clinical applications require careful patient selection and ongoing safety monitoring to balance therapeutic outcomes.
What are the potential risks and benefits of gene therapy targeting telomere disorders?
Gene therapy for telomere disorders offers significant therapeutic benefits but carries important risks that clinicians must understand. The primary benefit includes restoration of cellular function in patients with critically short telomeres.
Telomere gene therapy can reverse tissue degeneration[12] and restore chromosomal stability in aging cells. Patients with telomere biology disorders often experience improved organ function and reduced cellular senescence following treatment.
The main risk involves potential oncogenesis. Cancer cells frequently reactivate telomerase to achieve immortalization, which means upregulating these same pathways could promote tumor development.
Studies show that 85% of cancer patients have reactivated telomerase[12], highlighting this concern. However, research suggests transient expression may circumvent cancer risks compared to constitutive activation.
Vector-related risks include immune responses and off-target effects. These complications require careful patient monitoring and risk assessment protocols.
How might gene therapy affect the longevity of patients with telomere biology disorders?
Gene therapy targeting telomeres has demonstrated measurable longevity improvements in preclinical studies. Research shows promising results for extending both health span and lifespan in treated subjects.
AAV9 vector expressing TERT improved longevity in aging mice[12] by 13-20% in maximum lifespan measurements. Treated animals showed reduced age-related osteoporosis and improved neuromuscular function.
The therapy appears to work by preventing cellular senescence and maintaining chromosomal stability. Patients with telomere biology disorders typically experience premature aging due to critically short telomeres.
Longevity benefits may vary based on treatment timing and patient age. Some research indicates that therapeutic windows may be critical for optimal outcomes.
Early intervention could provide greater longevity benefits than treatment in advanced disease stages. However, human clinical data remains limited compared to animal studies.
What are the symptomatic manifestations that indicate a patient might benefit from telomere-targeted gene therapy?
Patients with telomere biology disorders present with specific clinical patterns that suggest potential benefit from gene therapy. These symptoms reflect the underlying cellular dysfunction caused by critically short telomeres.
Telomere biology disorders require algorithmic clinical approaches[2] for proper diagnosis and management. Clinicians use telomere length measurements and genetic testing to identify suitable candidates.
Hematopoietic symptoms include bone marrow failure, aplastic anemia, and abnormal blood cell counts. These manifestations often appear early in the disease course.
Pulmonary fibrosis represents a common and serious complication. Patients may develop progressive lung scarring and breathing difficulties that worsen over time.
Liver dysfunction and cirrhosis can occur without traditional risk factors. Some patients develop hepatopulmonary syndrome or portal hypertension.
Premature graying, nail abnormalities, and oral leukoplakia may provide early clinical clues. These mucocutaneous features often precede more serious organ involvement.
How is gene therapy advancing in the treatment of dyskeratosis congenita and other telomere biology disorders?
Recent clinical trials have shown promising early results for telomere biology disorder treatments. The first gene therapy trial for telomere biology disorders shows encouraging outcomes[1] in initial patient cohorts.
Elixirgen Therapeutics has reported positive results from their first two treated patients. This represents a significant milestone in translating laboratory research into clinical applications.
TERT gene therapy is particularly attractive for treating human telomere syndromes[14] associated with telomerase mutations and short telomeres. Current approaches focus on restoring telomerase function in affected cells.
Vector development has improved significantly with adeno-associated virus platforms. AAV9 shows particular promise due to its ability to transduce multiple tissue types effectively.
Clinical protocols now incorporate comprehensive safety monitoring systems. These include regular telomere length measurements and cancer surveillance protocols.
What are the current costs and accessibility challenges associated with telomere gene therapy treatments?
Gene therapy treatments typically involve substantial costs that present significant accessibility barriers. These expenses reflect the complex manufacturing processes and specialized clinical care required.
Gene therapy involves complex care extending over several months[15], requiring extensive medical support and monitoring. Patients need multiple hospital visits and specialized testing procedures.
Manufacturing costs for custom vectors remain extremely high. Each treatment requires specialized production facilities and quality control measures that increase expenses.
Insurance coverage varies significantly between providers and geographic regions. Many insurance plans do not yet cover experimental telomere therapies due to limited long-term data.
Geographic accessibility creates additional challenges for patients. Treatment centers with telomere expertise remain concentrated in major medical centers.
Patient travel and accommodation costs add substantial financial burden. Families often need to relocate temporarily for treatment and follow-up care.
How do clinical trials assess the efficacy and safety of telomerase gene therapy in humans?
Clinical trials for telomerase gene therapy employ rigorous protocols to evaluate both therapeutic benefits and potential risks. These studies use multiple assessment methods to track patient outcomes over extended periods.
Clinical approaches include measuring telomere length and testing for genetic mutations[2] throughout the treatment process. Researchers monitor both germline and somatic mutations that could indicate complications.
Safety assessments focus heavily on cancer surveillance protocols. Investigators conduct regular imaging studies and tumor marker evaluations to detect any malignant transformations.
Efficacy measurements include organ-specific function tests and quality of life assessments. Researchers track improvements in bone marrow function, pulmonary capacity, and liver enzymes.
[Comprehensive guidelines exist for telomere biology disorder diagnosis]
References
- First Gene Therapy Trial for Telomere Biology Disorders Shows Promising Results. https://scienceblog.cincinnatichildrens.org/first-gene-therapy-trial-for-telomere-biology-disorders-shows-promising-results/ Accessed December 2, 2025
- Telomere Biology Disorders - Center for Individualized Medicine. https://www.mayo.edu/research/centers-programs/center-individualized-medicine/patient-care/telomere-biology-disorders Accessed December 2, 2025
- Telomere biology disorders. https://www.nature.com/articles/s41525-021-00198-5 Accessed December 2, 2025
- Dyskeratosis congenita represents one of the most well-known TBDs. https://scienceblog.cincinniachildrens.org/first-gene-therapy-trial-for-telomere-biology-disorders-shows-promising-results/ Accessed December 2, 2025
- Just a moment.... https://ashpublications.org/blood/article/140/Supplement%201/13078/488475/Publication-of-Second-Edition-Telomere-Biology Accessed December 2, 2025
- Just a moment.... https://ashpublications.org/hematology/article/2023/1/563/506396/Clinical-manifestations-of-telomere-biology Accessed December 2, 2025
- Inherited Telomere Biology Disorders: Pathophysiology, Clinical Presentation, Diagnostics, and Treatment. https://pmc.ncbi.nlm.nih.gov/articles/PMC11452174/ Accessed December 2, 2025
- Recent advances in understanding telomere diseases. https://pmc.ncbi.nlm.nih.gov/articles/PMC9586155/ Accessed December 2, 2025
- Just a moment.... https://trial.medpath.com/news/8fd4d21ad54dadce/fda-grants-rmat-designation-to-elixirgen-s-novel-gene-therapy-for-rare-telomere-disorders Accessed December 2, 2025
- Elixirgen Therapeutics Publishes Early Results Showing Telomere Elongation in First Gene Therapy Trial for Telomere Biology Disorders • Elixirgen.... https://elixirgentx.com/elixirgen-therapeutics-publishes-early-results-showing-telomere-elongation-in-first-gene-therapy-trial-for-telomere-biology-disorders/ Accessed December 2, 2025
- A Next-Generation RNA Therapy Targets Telomere Disorders. https://globalgenes.org/raredaily/a-next-generation-rna-therapy-targets-telomere-disorders/ Accessed December 2, 2025
- Telomere Gene Therapy: Polarizing Therapeutic Goals for Treatment of Various Diseases. https://pmc.ncbi.nlm.nih.gov/articles/PMC6563133/ Accessed December 2, 2025
- ScienceDirect. https://www.sciencedirect.com/science/article/pii/S0024320525005399/ Accessed December 2, 2025
- Telomere-driven diseases and telomere-targeting therapies. https://pmc.ncbi.nlm.nih.gov/articles/PMC5379954/ Accessed December 2, 2025
- Gene therapy involves complex care extending over several months. https://www.mda.org/sites/default/files/2025/03/Gene-Therapy-A-Guide-for-What-to-expect.pdf Accessed December 2, 2025